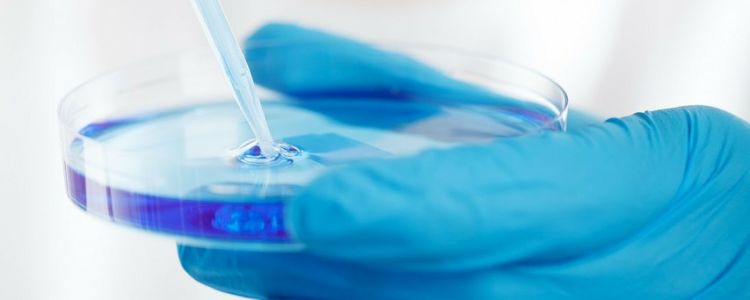
Цей новий метод редагування генів може виявляти помилки КРІСПРу

Цей новий метод редагування генів може виявляти помилки КРІСПРу
Hедагування редактора
Інструмент для редагування генів CRISPR вже використовується вченими всього світу, які беруть участь в лікуванні смертельних захворювань, редагуючи геноми пацієнтів. Однак, оскільки людські випробування для різних методів лікування планується почати, ми як і раніше стикаємося з перешкодою для забезпечення того, щоб будь-які помилки в змінах CRISPR не викликали проблем. Вчені з Техаського університету в Остіні, можливо, придумали можливе рішення. Вони розробили щось, що працює як інтелектуальний редактор для CRISPR: метод для прогнозування і пастки помилок інструменту, оскільки він працює, тим самим дозволяючи редагувати помилки, що викликають хвороби, з геномів.
Вчені вже навчилися використовувати CRISPR для редагування помилок майже в будь-якому геномі - і саме ці помилки можуть викликати широкий спектр захворювань. Багато форм раку, хвороба Хантінгтона і навіть ВІЛ можуть бути націлені на використання CRISPR. При цьому це не ідеальне рішення. Подібно до того, як автокоррекция на вашому смартфоні може призвести до випадкового і незручному текстового повідомлення, CRISPR може «виправити» те, що було насправді правильно, наслідки якого можуть зробити його небезпечною помилкою. Той, який насправді викликає захворювання, а не бентежить соціальний напад.
Дослідники розробили метод швидкого тестування молекули CRISPR проти всього генома людини, а не тільки цільової області, щоб передбачити інші сегменти ДНК, з якими може випадково взаємодіяти інструмент. Цей новий метод функціонує як система раннього попередження, надаючи лікарям можливість більш точно адаптувати методи лікування генів до конкретних пацієнтам, забезпечуючи при цьому їх ефективність і безпеку.
«Якщо ми збираємося використовувати CRISPR для поліпшення здоров'я людей, нам потрібно переконатися, що ми мінімізуємо побічний збиток, і ця робота показує, як це зробити», - сказав Стівен Джонс, постдокторські дослідник UT Austin і ко-лідер Автор дослідження, повідомив UT News.
Більш точні прогнози
Це дослідження також дозволить вченим поліпшити свої власні інтелектуальні навички, коли справа доходить до поведінки молекули CRISPR - навіть без тестування геному. Це пов'язано з тим, що робота дійсно показує, що «книга правил» CRISPR-молекули слідують, коли вони вибирають цілі.
Одна молекула CRISPR, випробувана групою, Cascade, націлює послідовності ДНК, але менше уваги приділяє кожної третьої букві в послідовності. «Отже, якби він шукав слово« сорочка »і замість цього знайшов слово« короткий », це може бути добре, - сказав Джонс, пояснюючи значення примхи в новинах UT.
Як дослідники освоюють ці правила, вони зможуть розробити більш прогностичні моделі для лікування CRISPR. Це зробить техніку більш швидкої і дешевої, що, в свою чергу, зробить персоналізовані генні терапії більш доступними для більшої кількості пацієнтів. Найголовніше, це також допоможе зробити весь процес набагато безпечніше.
Список літератури: Phys, UT News, Cell



